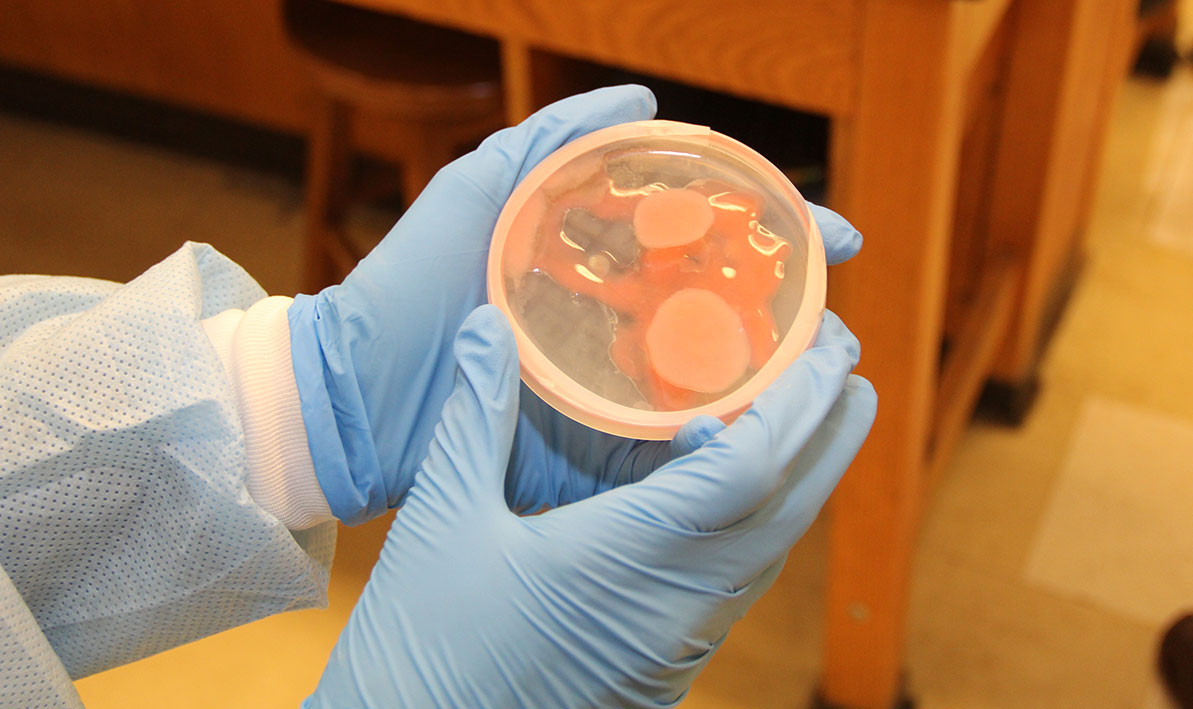

News Archive
Showing results 1-10 of 622
A Quiet Fire
Thursday, Nov. 21, 2024
CONNECTION SPECIAL: As executive director of the Massachusetts Commission on the Status of Women, HCC alum Shaitia Spruell ’14 leads by example.
Street Mythology
Friday, Nov. 15, 2024
The HCC Theater Department will present “Polaroid Stories,” a play by Naomi Iizuka that combines real-life stories of homeless youth with Greek myths, Nov. 21-23.
STEM Week 2024
Tuesday, Oct. 15, 2024
STEM Week at HCC runs from Oct. 21-24, with events and activites including agar art, origami, and mobius strip workshops, drone demonstrations, and cricket cookies.
Free Computer Classes
Friday, Sept. 27, 2024
Holyoke Community College is offering a free, remote, six-week beginner computer training course Oct. 9 through Nov. 25.
National Appointment
Thursday, Sept. 26, 2024
Vice President Sharale Mathis will serve on the Commission on Institutional Infrastructure and Transformation for the American Association of Community Colleges, a national advocacy group.
Foundation Leader
Tuesday, Sept. 24, 2024
HCC Vice President Amanda Sbriscia has been named to a national advisory board focusing on issues related to college and university foundations.
Igniting Success
Tuesday, Sept. 24, 2024
HCC received an award from the Massachusetts Rehabilitation Commission for a cybersecurity training program it runs in partnership with the state agency.
Summer 2024 Dean's List
Tuesday, Sept. 17, 2024
Holyoke Community College is proud to recognize all the students who made the Dean's List for the Summer 2024 term.
Family Literacy Week
Friday, Sept. 13, 2024
Family Story Night featuring President George Timmons to highlight activities recognizing National Adult Education and Family Literacy Week, Sept. 16-20.
A Cut Above
Thursday, Sept. 12, 2024
HCC held a ribbon-cutting ceremony to celebrate the reopening and expansion of the Thrive Center and Food Pantry in a brand new space in the Kittredge Center.